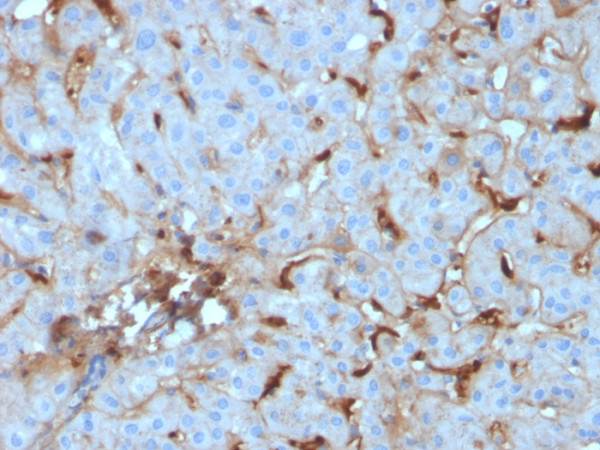
Anti-C1QA / Complement C1q A-Chain, clone C1QA/2955

Cookie preferences
This website uses cookies, which are necessary for the technical operation of the website and are always set. Other cookies, which increase the comfort when using this website, are used for direct advertising or to facilitate interaction with other websites and social networks, are only set with your consent.
Configuration
Technically required
These cookies are necessary for the basic functions of the shop.
"Allow all cookies" cookie
"Decline all cookies" cookie
CSRF token
Cookie preferences
Currency change
Customer-specific caching
FACT-Finder tracking
Individual prices
Selected shop
Session
Comfort functions
These cookies are used to make the shopping experience even more appealing, for example for the recognition of the visitor.
Note
Show the facebook fanpage in the right blod sidebar
Statistics & Tracking
Affiliate program
Conversion and usertracking via Google Tag Manager
Track device being used
| Item number | Size | Datasheet | Manual | SDS | Delivery time | Quantity | Price |
|---|---|---|---|---|---|---|---|
| NEO-712-MSM5-P0 | 20 µg | - | - |
Request delivery time estimate |
326.00€
|
||
| NEO-712-MSM5-P1 | 100 µg | - | - |
Request delivery time estimate |
704.00€
|
If you have any questions, please use our Contact Form.
You can also order by e-mail: info@biomol.com
Larger quantity required? Request bulk
You can also order by e-mail: info@biomol.com
Larger quantity required? Request bulk
Formulation: Purified Ab with BSA and Azide at 200ug/ml. Cellular Localization: Secreted.... more
Product information "Anti-C1QA / Complement C1q A-Chain, clone C1QA/2955"
Formulation: Purified Ab with BSA and Azide at 200ug/ml. Cellular Localization: Secreted. Positive Control: Human liver or kidney tissue (IHC). Chromosome Location: 1p36.12. Protein Function: Core component of the complement C1 complex, a multiprotein complex that initiates the classical pathway of the complement system, a cascade of proteins that leads to phagocytosis and breakdown of pathogens and signaling that strengthens the adaptive immune system (PubMed:12847249, PubMed:19006321, PubMed:24626930, PubMed:29449492, PubMed:3258649, PubMed:34155115, PubMed:6249812, PubMed:6776418). The classical complement pathway is initiated by the C1Q subcomplex of the C1 complex, which specifically binds IgG or IgM immunoglobulins complexed with antigens, forming antigen-antibody complexes on the surface of pathogens: C1QA, together with C1QB and C1QC, specifically recognizes and binds the Fc regions of IgG or IgM via its C1q domain (PubMed:12847249, PubMed:19006321, PubMed:24626930, PubMed:29449492, PubMed:3258649, PubMed:6776418). Immunoglobulin-binding activates the proenzyme C1R, which cleaves C1S, initiating the proteolytic cascade of the complement system (PubMed:29449492). The C1Q subcomplex is activated by a hexamer of IgG complexed with antigens, while it is activated by a pentameric IgM (PubMed:19706439, PubMed:24626930, PubMed:29449492). The C1Q subcomplex also recognizes and binds phosphatidylserine exposed on the surface of cells undergoing programmed cell death, possibly promoting activation of the complement system (PubMed:18250442) [The Uniprot Consortium]
| Keywords: | Anti-C1QA, Anti-Complement C1q subcomponent subunit A, 559 |
| Supplier: | NeoBiotechnologies |
| Supplier-Nr: | 712-MSM5 |
Properties
| Application: | IHC, WB |
| Antibody Type: | Monoclonal |
| Clone: | C1QA/2955 |
| Conjugate: | No |
| Host: | Mouse |
| Species reactivity: | human |
| MW: | 29 kD |
| Format: | Purified |
Database Information
| KEGG ID : | K03986 | Matching products |
| UniProt ID : | P02745 | Matching products |
| Gene ID : | GeneID 712 | Matching products |
Handling & Safety
| Storage: | +4°C |
| Shipping: | +4°C (International: +4°C) |
Caution
Our products are for laboratory research use only: Not for administration to humans!
Our products are for laboratory research use only: Not for administration to humans!
You will get a certificate here
Viewed